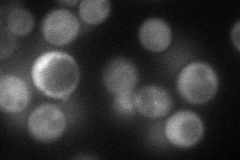
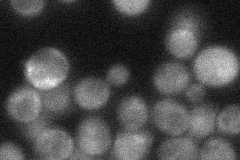
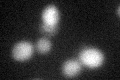
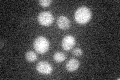

View description
Tyrosine phosphatase that plays a role in actin filament organization and endocytosis; localized to the cytoplasm
Localization:
Intensity:
Fold change:
Significance:
-
C’ GFP library in SD

cytosol27.66 -
N' NOP1pr-GFP in SD
cytosol57.8404 -
N' TEF2pr-mCherry in SD

cytosol60.3611 -
N' NATIVEpr-GFP in SD
cytosol30.8624 -
N' TEF2pr-VC and Cyto-VN in SD

cytosol38.3456 -
C’ GFP library in SD+DTT
cytosol25.380.91No -
C’ GFP library in SD+H2O2

cytosol29.751.07No -
C’ GFP library in Starvation Media
cytosol31.681.14No -
C’ GFP library on the background of Pup2-DaMP

cytosol -
C’ GFP library on the background of CCT mutant

cytosol26.5110.958162No
